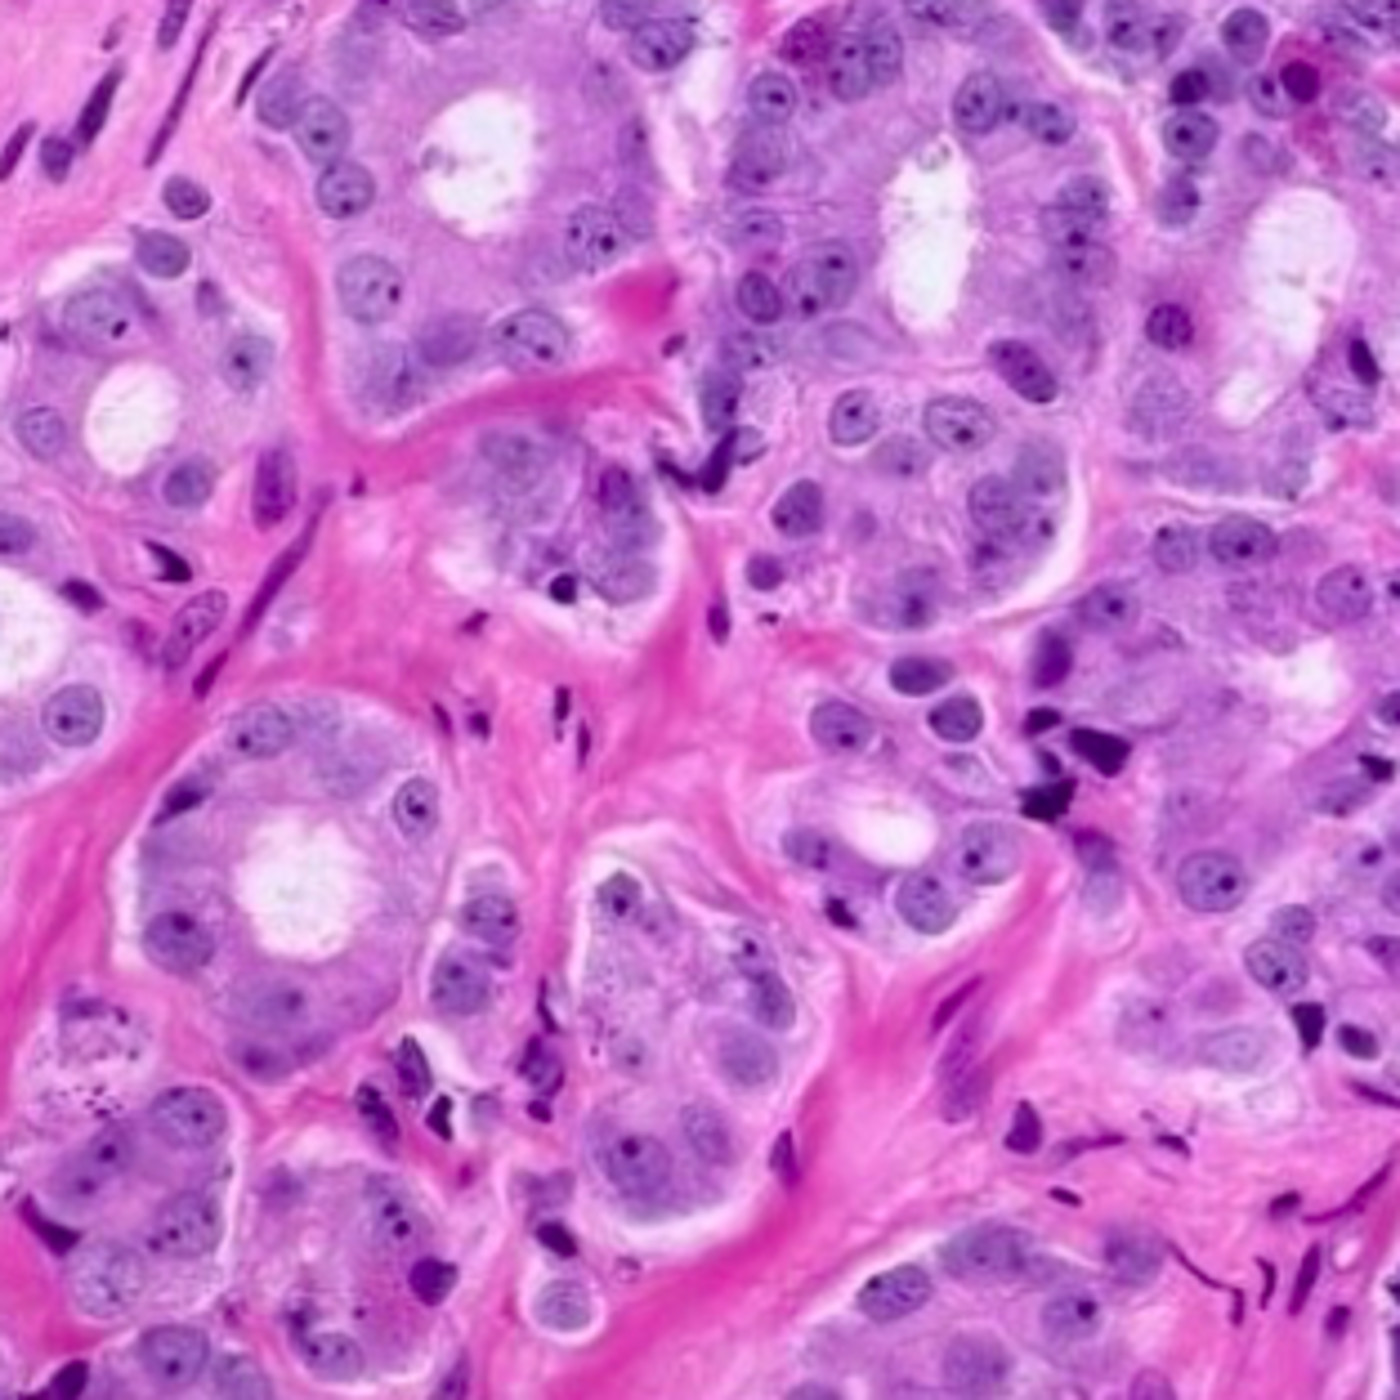
urolearning

Shows

urolearningCólico nefrítico ComplicadoCólico Nefrítico Complicado by Blanca Marly de Alós y Elena Echevarne.
2020-06-1306 min
urolearningCólico Nefrítico SimpleCólico Nefrítico Simple by Georgina Vidal- Abarca y Joan F. Cánovas
2020-06-1313 min
urolearningCasos clínicos de MASAS VESICALESCasos de Masas vesicales by Francesc Martí y Joan Felipe
2020-06-1313 min 2020-06-1314 min
2020-06-1314 min
urolearningSTUI. Síntomas de tracto urinario inferiorSTUI : Síntomas de tracto urinario inferior by Eduard Canela y Francesc Redondo.
2020-06-1307 min
urolearningPatología escrotal Benigna.Patología escrotal Benigna by Adrià Claramonte y Blanca Carrillo.
2020-06-1314 min
urolearningCasos clínicos de MASAS RENALESCasos clínicos de MASAS RENALES by Stephanie pirata y María Cuenca.
2020-05-1208 min
urolearningCasos Clínicos de incontinencia urinaria.Casos Clínicos de incontinencia urinaria: diagnostico diferencial , exploraciones complementarias, tratamiento .
By Aida Jiménez y Alicia Ortiz.
2020-05-1219 min
urolearningIncontinencia de orinaIncontinencia de orina de esfuerzo y por imperiosidad. By Maria Nicolau y Emma Vallribera.
2020-05-1213 min
urolearningTécnicas de estudioTécnicas de estudio by Anna Romero .
Rentabiliza tus horas dedicadas al estudio.
2020-05-1204 min
urolearningGestión del tiempoGestión del tiempo , planificación y organización by Mariona Segura, Marina Rodríguez y Rubén Bermejo .
2020-05-1207 min
urolearningMindfulness y gestión del estrés.Mindfulness y gestión del estrés by Paula Rodríguez y M. Mar Díaz.
Contiene una sesión guiada de Mindfulness.
2020-05-1213 min
urolearningInfertilidad MasculinaInfertilidad Masculina. Diagnostico diferencial , exploraciones complementarias y tratamiento by Liana Aráuxo y Laura Haro .
2020-05-1220 min
urolearningANDROLOGIACasos clínicos de andrología. Para saber más y entenderte mejor!
By Cristina Romero y Berta Grases.
2020-05-1213 min
urolearningCaso Clínico Tumor de PróstataUro Oncología:Caso Clínico Tumor de Próstata, by Sara Escudero , Marina Ramis y Teresa Jové.
2020-05-1207 min 2020-04-2712 min
2020-04-2712 min
urolearningPatología escrotal BenignaPatología escrotal Benigna by Adrià Claramonte y Blanca Carrillo.
2020-04-2714 min 2020-04-2708 min
2020-04-2708 min
urolearningTraumatismos Urológicos IITraumatismos urológicos II: renal y ureteral. By J.M. Guardiola y Javier Domenech.
2020-04-2712 min
urolearningTraumatismos Urológicos ITraumatismos Urológicos I: vesical , uretral , testicular. By Júlia Alerm y Queralt Vilaseca.
2020-04-2707 min 2020-04-2724 min
2020-04-2724 min
urolearningInfecciones Urológicas masculinas.Infecciones Urológicas masculinas: Orquitis, epididimitis , prostatitis. By Francina Rocamora y Andrea Hostench.
2020-04-2010 min
urolearningInfecciones Urinarias Graves.Infecciones Urinarias graves: Pielonefritis Xantogranulomatosa, Gangrena de Fournier etc . By Gerard Gistàs y Gerard Mora.
2020-04-2010 min
urolearningInfecciones urinarias no complicadasInfecciones Urinarias no complicadas: Cistitis, pielonefritis etc by M. Carmen González y Nausica Veà.
2020-04-2012 min
urolearningDerivaciones urinarias.Derivaciones Urinarias : sondas , catéteres, Nefrostomías. By Noa Pascual y Berta Serrallonga.
2020-04-2015 min
urolearningSondaje vesical y Tacto rectal .Sondaje vesical y Tacto rectal: Tipos de sondas e indicaciones de las mismas. Tacto rectal normal y patológico . By Meritxell Roca y Anna Jiménez.
2020-04-2009 min
urolearningHBP : TratamientoHiperplasia Benigna de Próstata: Descripción de los tratamientos. By Adriana Acha y Carla Rodríguez- Zanetti.
2020-04-2013 min
urolearningHBP: DiagnósticoHBP: Diagnóstico , exploraciones complementarias etc By Miriam Huterer y Laura Jovell.
2020-04-2009 min
urolearning¿ Qué es el PSA?EL PSA es un calicreina ¿ Dónde se fabrica? ¿ Para qué sirve? Este podcast te solucionará todas las dudas en cuanto al PSA. By Gemma Pujante y Victoria San Gil.
2020-04-2011 min
urolearningCISTECTOMÍA RADICAL Técnica quirúrgicaCISTECTOMÍA RADICAL Indicaciones y técnica quirúrgica. By Gemma Guiu y Laura Brustenga
2020-04-2006 min
urolearningNEFRECTOMÍA: Técnica quirúrgicaNefrectomía: Referencias anatómicas, indicaciones, técnica quirúrgica.By Iker Benegas y Pere Bibiloni.
2020-04-2031 min
urolearningTumores testicularesTumores testiculares: Diagnóstico y tratamiento by Angel Ribas y Carlos Mendoza.
2020-04-1513 min 2020-04-1511 min
2020-04-1511 min
urolearningTumor vesical infiltranteTumor vesical infiltrante: Diagnóstico y tratamiento . By Carla Andrés y Georgina Simó.
2020-04-1010 min
urolearningTumor vesical superficialTumor vesical superficial : Diagnóstico , tratamiento y seguimiento by Irene Loves y Julia Castaños.
2020-04-0711 min
urolearningTumor de Próstata diseminadoTumor de próstata diseminado: diagnóstico y tratamiento. By Mariona Videla, Laura Panés y Laia Angerri.
2020-04-0608 min
urolearningTumor de Próstata órgano confinadoTumores de Próstata órgano confinado : Diagnóstico, estudio de extensión y tratamiento by Néstor Navajas e Isabella Winstom.
2020-04-0506 min
urolearningTumores renalesUROLEARNING PODCAST: Diagnóstico y tratamiento de los tumores renales by Eduard Aranda y Ferran Grau
2020-04-0312 min
urolearningMalformaciones UreteralesMalformaciones congénitas ureterales: Reflujo vésico ureteral, duplicationes ureterales etc
2020-04-0107 min
urolearningAnatomía y semiología urológicaRepaso de la anatomía y semiología Urológica by Paulo Baraunda y Jesús Aguirrezabalaga.
2020-03-2722 min
urolearningMalformaciones renalesDescripción de las principales malformaciones congénitas renales.By Cristina Gener y Gemma Terns.
2020-03-2109 min
urolearningRAO vs RCODescripción de las causas de retención aguda y crónica de orina y su tratamiento . By Laura Ponce y Clara Raventós
2020-03-0809 min
urolearningRetención aguda de orina by Claudia AlcarazPodcast sobre casos clínicos: Rentención aguda de orina por HBP y diagnóstico diferencial
2020-02-1603 min
urolearningCÖLICO NEFÍTICO by Claudia AlcarazCaso clínico de cólico nefrítico : Diagnóstico y tratamiento
2020-02-0903 min
urolearningNefrología del trasplante renalDescripción de los aspectos nefrológicos del trasplante RENAL by Xavier Salvià.
2019-05-1911 min
urolearningLitiasis urinarias by Gerard CapellasResumen de la clase de Litiasis Urinaria: Diagnóstico y tratamiento.
2019-04-2123 min
urolearningProstatitis, Orquitis y Uretritis by Enric RosasRecorrido por las infecciones urológicas masculinas: Prostatitis, Uretritis y Orquitis.
2019-04-2111 min
urolearningInfecciones urinarias en la mujer by Sebastià RomagueraDescripción de las Infecciones Urinarias en la mujer.
2019-04-0712 min
urolearningUrgencias Urológicas by Pau RocaDiagnóstico y tratamiento de las principales Urgencias urológicas .
2019-03-3113 min
urolearningRadiología en Urología by Xenia SellarésDescripción de las pruebas radiológicas utilizadas en Urología.
2019-03-3108 min
urolearningRAO vs RCO by Mireia CullellDiagnóstico diferencial de retención aguda y crónica de orina , evaluación y tratamiento.
2019-03-3107 min
urolearningPatología peneana by Elena BrotonsResumen de las principales patologías peneanas y su tratamiento
2019-03-3110 min
urolearningAndrología by Elena BrotonsResumen de las principales patologías andrológicas y su tratamiento.
2019-03-3105 min
urolearningInfecciones Urogenitales GRAVESDescripción de las principales Infecciones Urogenitales graves
2019-03-2412 min
urolearningMalformaciones congénitas UrológicasDescripción detallada de las Malformaciones congénitas urológicas by Elena Abad
2019-03-2412 min 2019-03-2405 min
2019-03-2405 min 2019-03-2413 min
2019-03-2413 min 2019-03-2409 min
2019-03-2409 min
urolearningHBP Hiperplasia Benigna de Próstata.Fisiopatologogía , diagnóstico , tratamiento médico y tratamiento quirúrgico de la Hiperplasia Benigna de próstata.
2019-03-0312 min
urolearningTumores Vesicales InfiltrantesResumen de los tumores vesicales. Descripción detallada de los tumores vesicales músculo infiltrares.
2019-02-2410 min
urolearningAnatomía Patológica de los tumores renales.Anatomía Patológica de los tumores renales: Diagnóstico anátomo-patológico.
2019-02-1808 min
urolearningClase de Anatomía Patológica de Tumores prostáticos.Clase de Anatomía Patológica de Tumores prostáticos: Repaso de los conceptos básicos.
2019-02-1814 min
urolearningTumores prostáticos T1-T2Tumores prostáticos : Generalidades , Diagnóstico y Tratamiento de los T1-T2.
2019-02-1805 min
urolearningTumores prostáticos T3, T4 y Diseminado.Revisión de los tumores prostáticos: Diagnóstico y tratamiento de los T3, T4 y tumores diseminados.
2019-02-1810 min
urolearningTumores testiculares. GeneralidadesEn este audio se hace un repaso de los tumores testiculares .
2019-02-1806 min
urolearningTumores Vesicales. GENERALIDADESEste podcast ha sido usado para Flipped learning de la clase de tumores Uroteliales.
2019-02-1706 min
urolearningTumores RENALES. ResumenEste podcast es un Miniresumen de la clase de Tumores renales.
Utilizado para Flipped Learning .
2019-02-1702 min